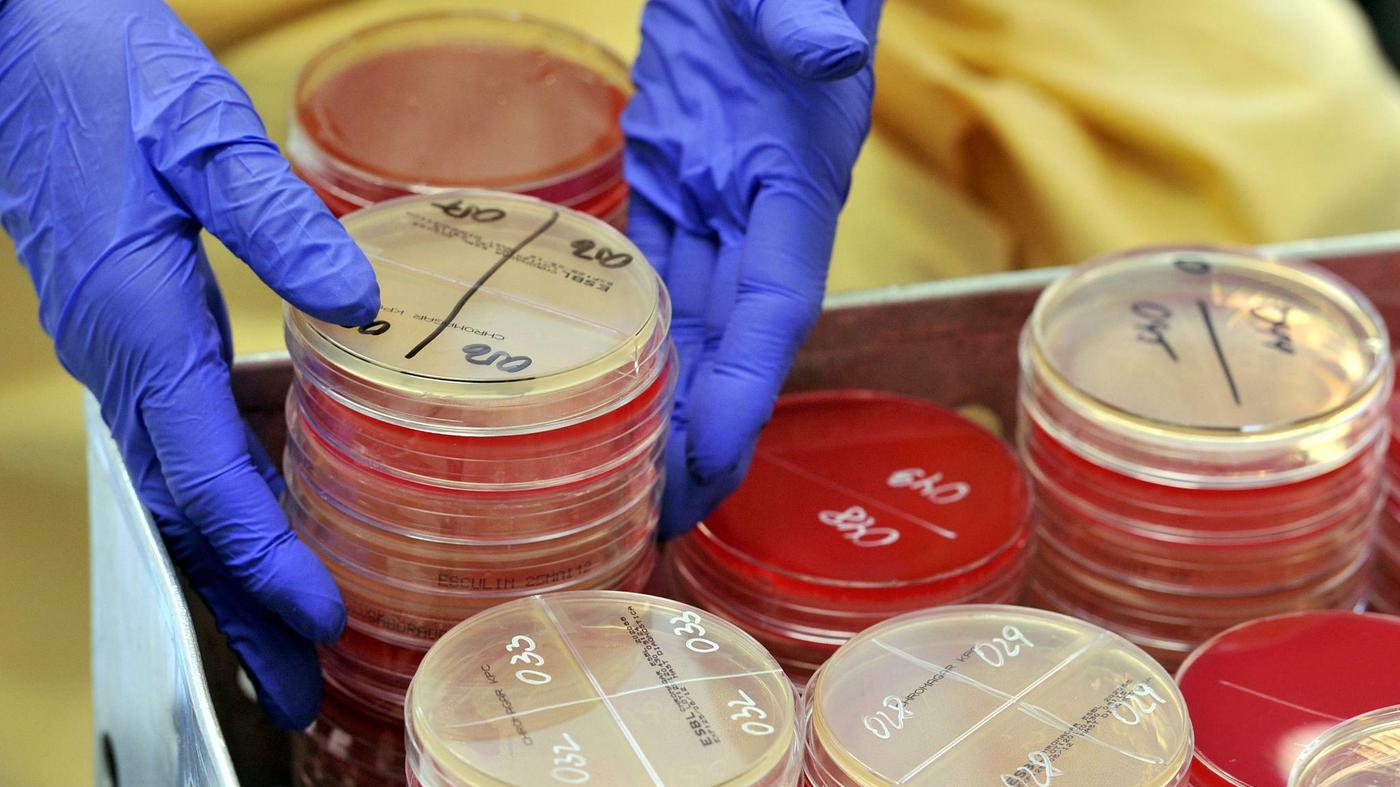
Resistente Keime Todbringendes Souvenir

Die Keimruhe ist eine Form der Dormanz (Entwicklungsverzögerung), die sowohl bei Pflanzen als auch bei Tieren auftritt. Bei Säugetieren spricht man auch von Vortragezeit, während für Vögel der Begriff Eiruhe verwendet werden kann.
Tierarten stoppen bei der Keimruhe die embryonale Entwicklung, zwischen der Befruchtung und der Geburt. Diese Keimruhe, während der die Trächtigkeit pausiert, wird auch als Vortragezeit bezeichnet und tritt bei zahlreichen Wildtieren, wie z. B. Bären, Robben, Seelöwen und Rehen auf.
Es wird zwischen einer optionalen bzw. fakultativen und einer obligaten Keimruhe unterschieden, die unabhängig von äußeren Bedingungen eintritt.
Keimruhe bei Tieren
Ablauf und Gründe
Bei Tieren bezeichnet Keimruhe das Phänomen, dass eine befruchtete Eizelle eines Tieres sich nicht sofort kontinuierlich zum Embryo weiterentwickelt. Die befruchtete Eizelle (Zygote) nistet sich zwar in der Gebärmutterschleimhaut ein, teilt sich aber zunächst nicht.
Erst nach der Keimruhe schreitet die embryonale Entwicklung normal fort. Die dadurch verlängerte Tragzeit ermöglicht die Geburt zu einer günstigeren Jahreszeit mit besseren Nahrungsangebot, oder zu einem Zeitpunkt, wenn kein weiteres Jungtier mehr auf die Versorgung durch das Muttertier angewiesen ist.
Beispiele für Tiere, die Keimruhe praktizieren
Insgesamt ist von über 130 Säugetierarten bekannt, dass sie Keimruhe praktizieren, darunter Bären, Robben, Seelöwen und mehrere Arten von Beuteltieren.
Beim Reh etwa erfolgt die Befruchtung während einer viertägigen Phase zwischen Mitte Juli und Mitte August, nur gut zwei Monate nach der Geburt des Kitzes. Aber erst 5 Monate später, etwa im Dezember oder Januar, beginnt das embryonale Wachstum. Dadurch verlängert sich die Tragzeit und die Kitze kommen im darauffolgenden Mai oder Juni zur Welt, so dass Mutter und Jungtier sofort von einem reichen Nahrungsangebot profitieren.
In Europa kommt die Keimruhe auch beim Dachs, Marder, Hermelin, Seehund und beim Braunbär vor. Auch dem eurasischen Fischotter wird bisweilen Keimruhe zugesprochen, doch basiert dies auf einer Verwechslung mit dem kanadischen Flussotter. Besonders lang im Verhältnis zur eigentlichen Tragzeit ist die Keimruhe bei Beuteltieren.
Keimruhe bei Pflanzen
Bei Pflanzen des gemäßigten Klimas ist die Keimruhe (Dormanz) der ausgereiften Samen die Regel. Durch diesen Schutzmechanismus der Pflanzen wird der klimatischen Saisonalität dahingehend Rechnung getragen, dass die Keimung zu einer günstigen Jahreszeit erfolgt und der Keimling optimale Wachstumschancen vorfindet.
Die Zeitdauer der Keimruhe ist bei den einzelnen Pflanzenarten sehr unterschiedlich, ebenso wie die Faktoren, die zum Abbau der Keimruhe führen. Als Einflussfaktoren sind zu nennen: Feuchtigkeit, Temperaturschwankungen, Lichtverhältnisse und Nährmedium (Boden).
Die Keimruhe muss beendet sein, wenn Saatgut in das Saatbett ausgebracht wird. Während die Keimruhe bei Roggen nur wenige Tage nach der Reifung endet, beträgt sie bei Weizen und Gerste mehrere Wochen, Apfelkerne keimen sogar erst nach einer winterlichen Frosteinwirkung. Der künstliche Abbau der Keimruhe wird in diesem Fall als Stratifikation bezeichnet.
Siehe auch
- Lichtkeimer
- Vernalisation
- Winterruhe
Literatur
- Ernst Klapp: Lehrbuch des Acker- und Pflanzenbaus. 5. Auflage. Parey, Berlin 1958.
Einzelnachweise
![]()


